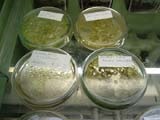

Reproducerea Spore de ferigi

În primul rând, trebuie să citiți, cel puțin în termeni generali, ciclul de viață al structurii și ferigi. În acest scop, potrivit chiar și manual școală botanică. Deci, eu nu am de gând să descrie bine cunoscute fapte.
Deci, toate în ordine.
Cum se colectează sporii?


Prima metodă
Se aplică în cazurile în care este posibil să se taie sporonosyaschuyu Vayu (așa-numita feriga), sau o porțiune a acesteia. Este important doar să se asigure că Sori (grupuri de sporangiospori) pe maturată sale, dar sporangiospori (formarea sferică în interiorul care formează spori) încă nu a fost dezvăluit. Aceste Sori, în cele mai multe cazuri, uite maro auriu. Piese de tăiat wai pus într-o pungă. Dacă nu se poate potrivi întreaga frondei, am elimina rahisului și tăiat acele părți ale acestuia, care nu sori.
Este obligatoriu să indice următoarele informații sac:
Numele de plante (dacă nu este cunoscută, numărul de înregistrare);
Care conține spori (idee bună să scrie și care au colectat);
Data de colectare.
Și astfel, în saci, ei pot sta jos pentru o lungă perioadă de timp (unele specii de mai multe decenii), fără a pierde viabilitatea. Dar chiar dacă nu este nevoie de a păstra dezbaterea, și eu vreau ca ei să semene imediat după colectare, nu va grabiti. Lăsați-i să se întindă într-o pungă, și punga într-un loc cald și uscat, cel puțin o săptămână. De ce? Numai atunci când sporangiospori uscat deschis și disputele verse din ele.
A doua modalitate
Eu folosesc în cazul în care nu este posibil să se taie Vayu. De exemplu, în cazul în care proprietarul instalației nu vrea să strice aspectul său. Am tratat acest lucru cu înțelegere. Doar deschide geanta, l-am prezentat la partea de jos și racla Valle SORUS pentru perie rigid Sori, și, uneori, chiar și cu un cuțit, astfel încât toate fragmentat a căzut direct într-un sac. Desigur, ar trebui să încercați să nu deteriora chiar Vayu.
Tot ce ar putea îndepărta pământul în sac tot drumul - o săptămână. Când în interiorul sacului au fost deschise sporangiospori, iar disputele verse din ele, pot fi semănate.
Cum să semene controverse
Este timpul pentru a planta. Deplierea pungii, îndepărtați particulele mai mari (resturile wai), restul este particule fine (este fragmente mici wai și sporangiospori) și ceva galben-brun praf.

Am avut ocazia de a experimenta multe diferite, uneori chiar exotice, însămânțarea metode de dispută: pe lemnul carbonizat pe oala de lut răsturnată pe concasată și comprimată mușchi Sphagnum pe nisip, pe piaflor pe cipuri din cărămidă, parțial imersate în soluția nutritivă, etc. Ultimul ma învățat pteridolog Vidya Laxmi Gurung în Nepal. Nu știu de ce nu folosesc această metodă? Este foarte convenabil. Pentru bulb, cărămidă sfărâmată și soluție nutritivă, de exemplu, soluție Knopp. Brick se toarnă în balon, se umple cu o soluție, astfel încât caramida a fost doar parțial scufundat în ea. Top pour dispute. Se închide dopul de bumbac-tifon și a pus într-un loc luminos și cald. Prothallia format pe ruinele unei cărămizi, să adere la l rizomi. Când mânuirea sabiei tinere ferigi, a luat o bucăți de cărămidă cu forcepsul și le-a pus în rânduri, împingând ușor pe teren.
După ce a încercat diferite opțiuni, am ales două moduri de a spori de semănat, care sunt utilizate în funcție de sarcina.
Prima metodă

MgSO4 * 7H2O. 0,10 g
K2HPO4. 0,20 g
KNO3. 1,0 g
Ca (NO3) 2 * 4H2O. 0,10 g
Suma menționată este dizolvată în 1 l. de apă și se adaugă 1 picătură de soluție FeCl3 1%. Fit și doar o soluție slabă de orice îngrășăminte complexe. Sporii nu se scufunda, iar dezvoltarea prothallia are loc pe suprafața de soluție. Dacă este necesar, în orice etapă a soluției cu zarotkami pur și simplu turnat pe suprafața solului, în cazul în care acestea continuă să se dezvolte. Dar aceasta este a doua metodă.


-L folosesc când vreau doar să se propage o ferigă. În acest scop, sporii au fost însămânțate pe suprafața solului compactat, care este pre-sterilizate într-o baie de apă. Deoarece substratul este cel mai potrivit pentru majoritatea tipurilor de amestec de mucegai de frunze și turbă în raportul de 1: 1. Dar ar putea exista o varietate de experimente. Deci, de exemplu, ferigi de roci bune pentru a adăuga un miez de cărămidă, și pentru calcicole - cretă.
După abur solul este umed optim. Ca atare, o am și pus în recipiente pentru alimente de unică folosință. Este important în containere este bine compactat si nivelat. Când ați terminat, pur și simplu să toarne uniform sporilor la suprafața solului. Am semna și închideți capacul pe recipient. Udarea nu este necesară.
Într-un cald (20-25 ° C) și locul de lumină 10-15 zile după sporii încep să germineze. În câteva săptămâni pe suprafața substratului apare patină verde strălucitor. În funcție de densitatea de semănat, care este aproape imposibil să se adapteze, și de la germinare, răsaduri poate fi atât foarte rare și foarte dens.




Când prothallia a atins un diametru de aproximativ 5 mm. acestea sunt gata pentru fertilizare. În acest moment, este timpul pentru a începe prin pulverizare lor de la un jet de apă caldă. Această procedură trebuie să fie repetată de 5-6 ori la intervale de o dată pe săptămână.

După cum puteți vedea, nimic complicat. Sper că cineva ar îndrăzni să încerce să vă crească o nouă ferigă în acest fel. Voi fi bucuros să primească comentarii cu privire la acest articol, și rapoartele privind rezultatele experimentelor lor.